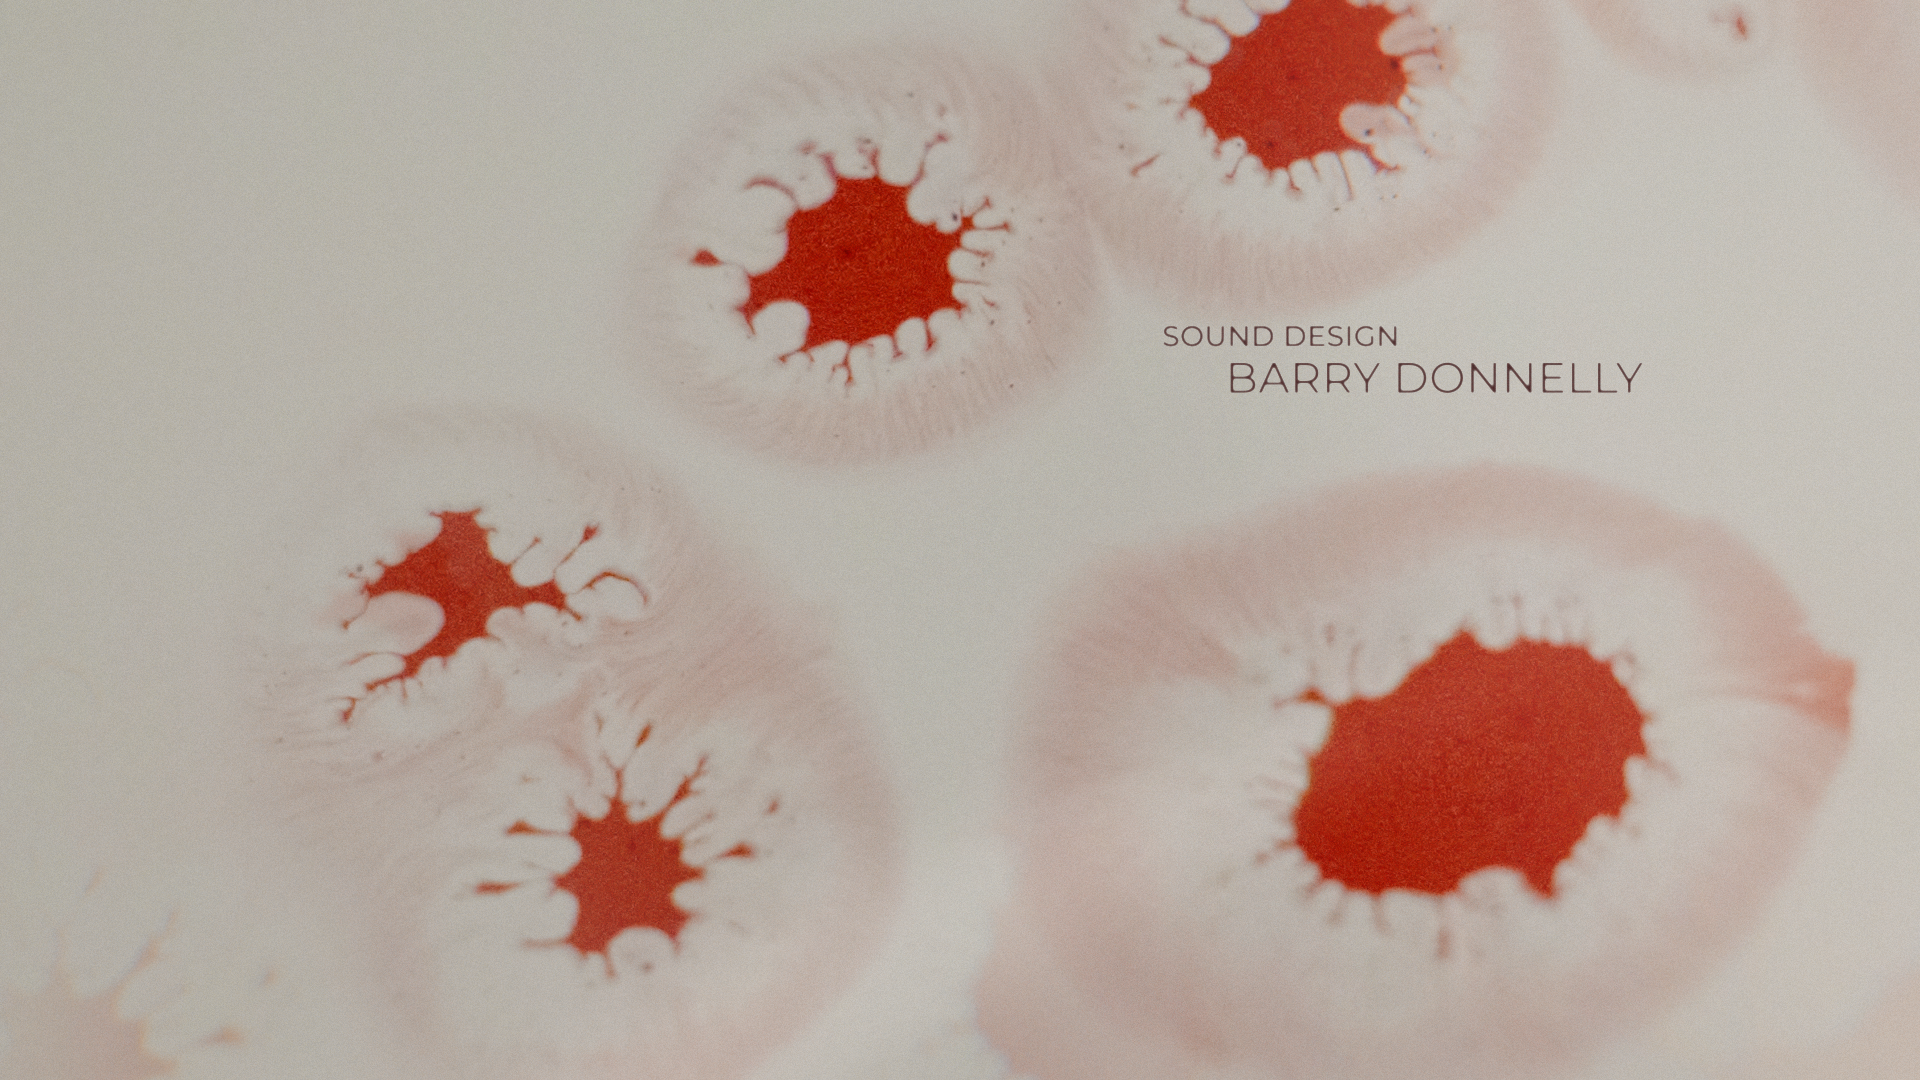

Motion Graphics
[My Octopus Teacher] Title Sequence
Title sequence design for the documentary My Octopus Teacher on Netflix.
I used ink and liquid acrylic to mimic the characteristics of the chromatophores of octopus and its behaviors in abstract and visual ways.
Music is from the original movie sound track.
Title sequence design for the documentary My Octopus Teacher on Netflix.
I used ink and liquid acrylic to mimic the characteristics of the chromatophores of octopus and its behaviors in abstract and visual ways.
Music is from the original movie sound track.

©2024 Alicia Liu